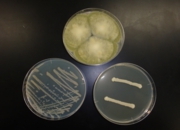

日時: 2013年8月28日(水) 13:00-15:00
場所: 筑波大学 第二エリア 2D棟309室
共催: 筑波大学
協賛: (独)製品評価技術基盤機構、ノボザイムズ ジャパン(株)、
講師: 安藤 勝彦 先生 (独)製品評価技術基盤機構
参加人数: 44名(児童 16名、同伴者 14名、講師 1名、幹事 5名、お手伝い 8名)
筑波大学に会場を移して2度目の開催でしたが、関東4都県から16名の児童が参加してくれました。「もやしもん」のおかげで微生物に詳しい子供たちが出現し、この夏休みだけでも微生物・きのこ関係のセミナーに参加するのが3回目という子もいました。日本の微生物学者の将来は明るいのではないでしょうか。そんな子供たちにも、本格的な顕微鏡を使った微生物観察は大変魅力的だったようで、皆熱心に観察を繰り返し、微生物の形や大きさを学んでいました。麹菌、パン酵母、納豆菌、どれも身近な微生物ですが、実際に眼で見る機会は滅多にありません。一部の子供たちからは「家にある顕微鏡よりも良く見える。」と好評でした。
次の楽しみは、自分たちが採集した微生物との対面です。標準的な寒天プレートに思い思いのものを入れてもらう企画ですが、子供たちなりに良く考えて様々な物を試していました。食用きのこの切片やヨーグルトを入れてきたおませな子供たちもいました。ともあれ、ここで皆、空気中や体の表面にも微生物がいること、微生物はどこにでもいることを納得してくれたようです。
このほかは、安藤先生の楽しいお話から、微生物が地球の掃除屋さんであること、自分たちの食べ物や薬などを作ってくれる「働きもの」であることをしっかり学びました。
「また参加したい」「中学生用のスクールもやって欲しい」といううれしい感想を寄せてくれる子供たちがいて、企画側としてはなんとも幸せなひと時でした。また来年も続けたいと思います。次回はついに10周年となります。
参加してくれた子供たちの感想文:
- 僕は、微生物のサマースクールで微生物がどんな働きをしているか分かりました。一番面白かったのは、微生物を観察したことです。理由は色々な形の微生物がいるからです。驚いたことは、カビが7600属70000種という多さでした。今日微生物のサマースクールに来て良かったです。(小4)
- 今日私が分かったことは、「地球上に微生物はどこにでもいる。」と言うことです。こけ・空気・食べ物にもいっぱい入っていると言う事にもすごくびっくりしました。顕微鏡で微生物を見て、色々な形でそれぞれ違ったので、人間と似ているなぁとも思いました。この授業はすごく楽しかったです。(小5)
- 微生物は色々な種類がいるのが分かった。カビ、コウボ、バクテリアはとても小さいことが分かって、見た時にバクテリアはよく動いていました。最初に見た時に、少し気持ちがわるかったけれど、形が面白かったです。(小5)
- 微生物の実験をして分かったことは、地球上にはものすごい数の生き物がいるということです。今まで、狭い範囲の微生物しか知りませんでしたが、身の周りには、色々な種類の微生物がいました。実験をやって、初めて活躍を知ったのもありました。実験をやって、楽しかったです。微生物のいいところを知ることができました。(小6)
![]() |
![]() |
![]() |
![]() |
![]() |
![]() |
![]() |
![]() |